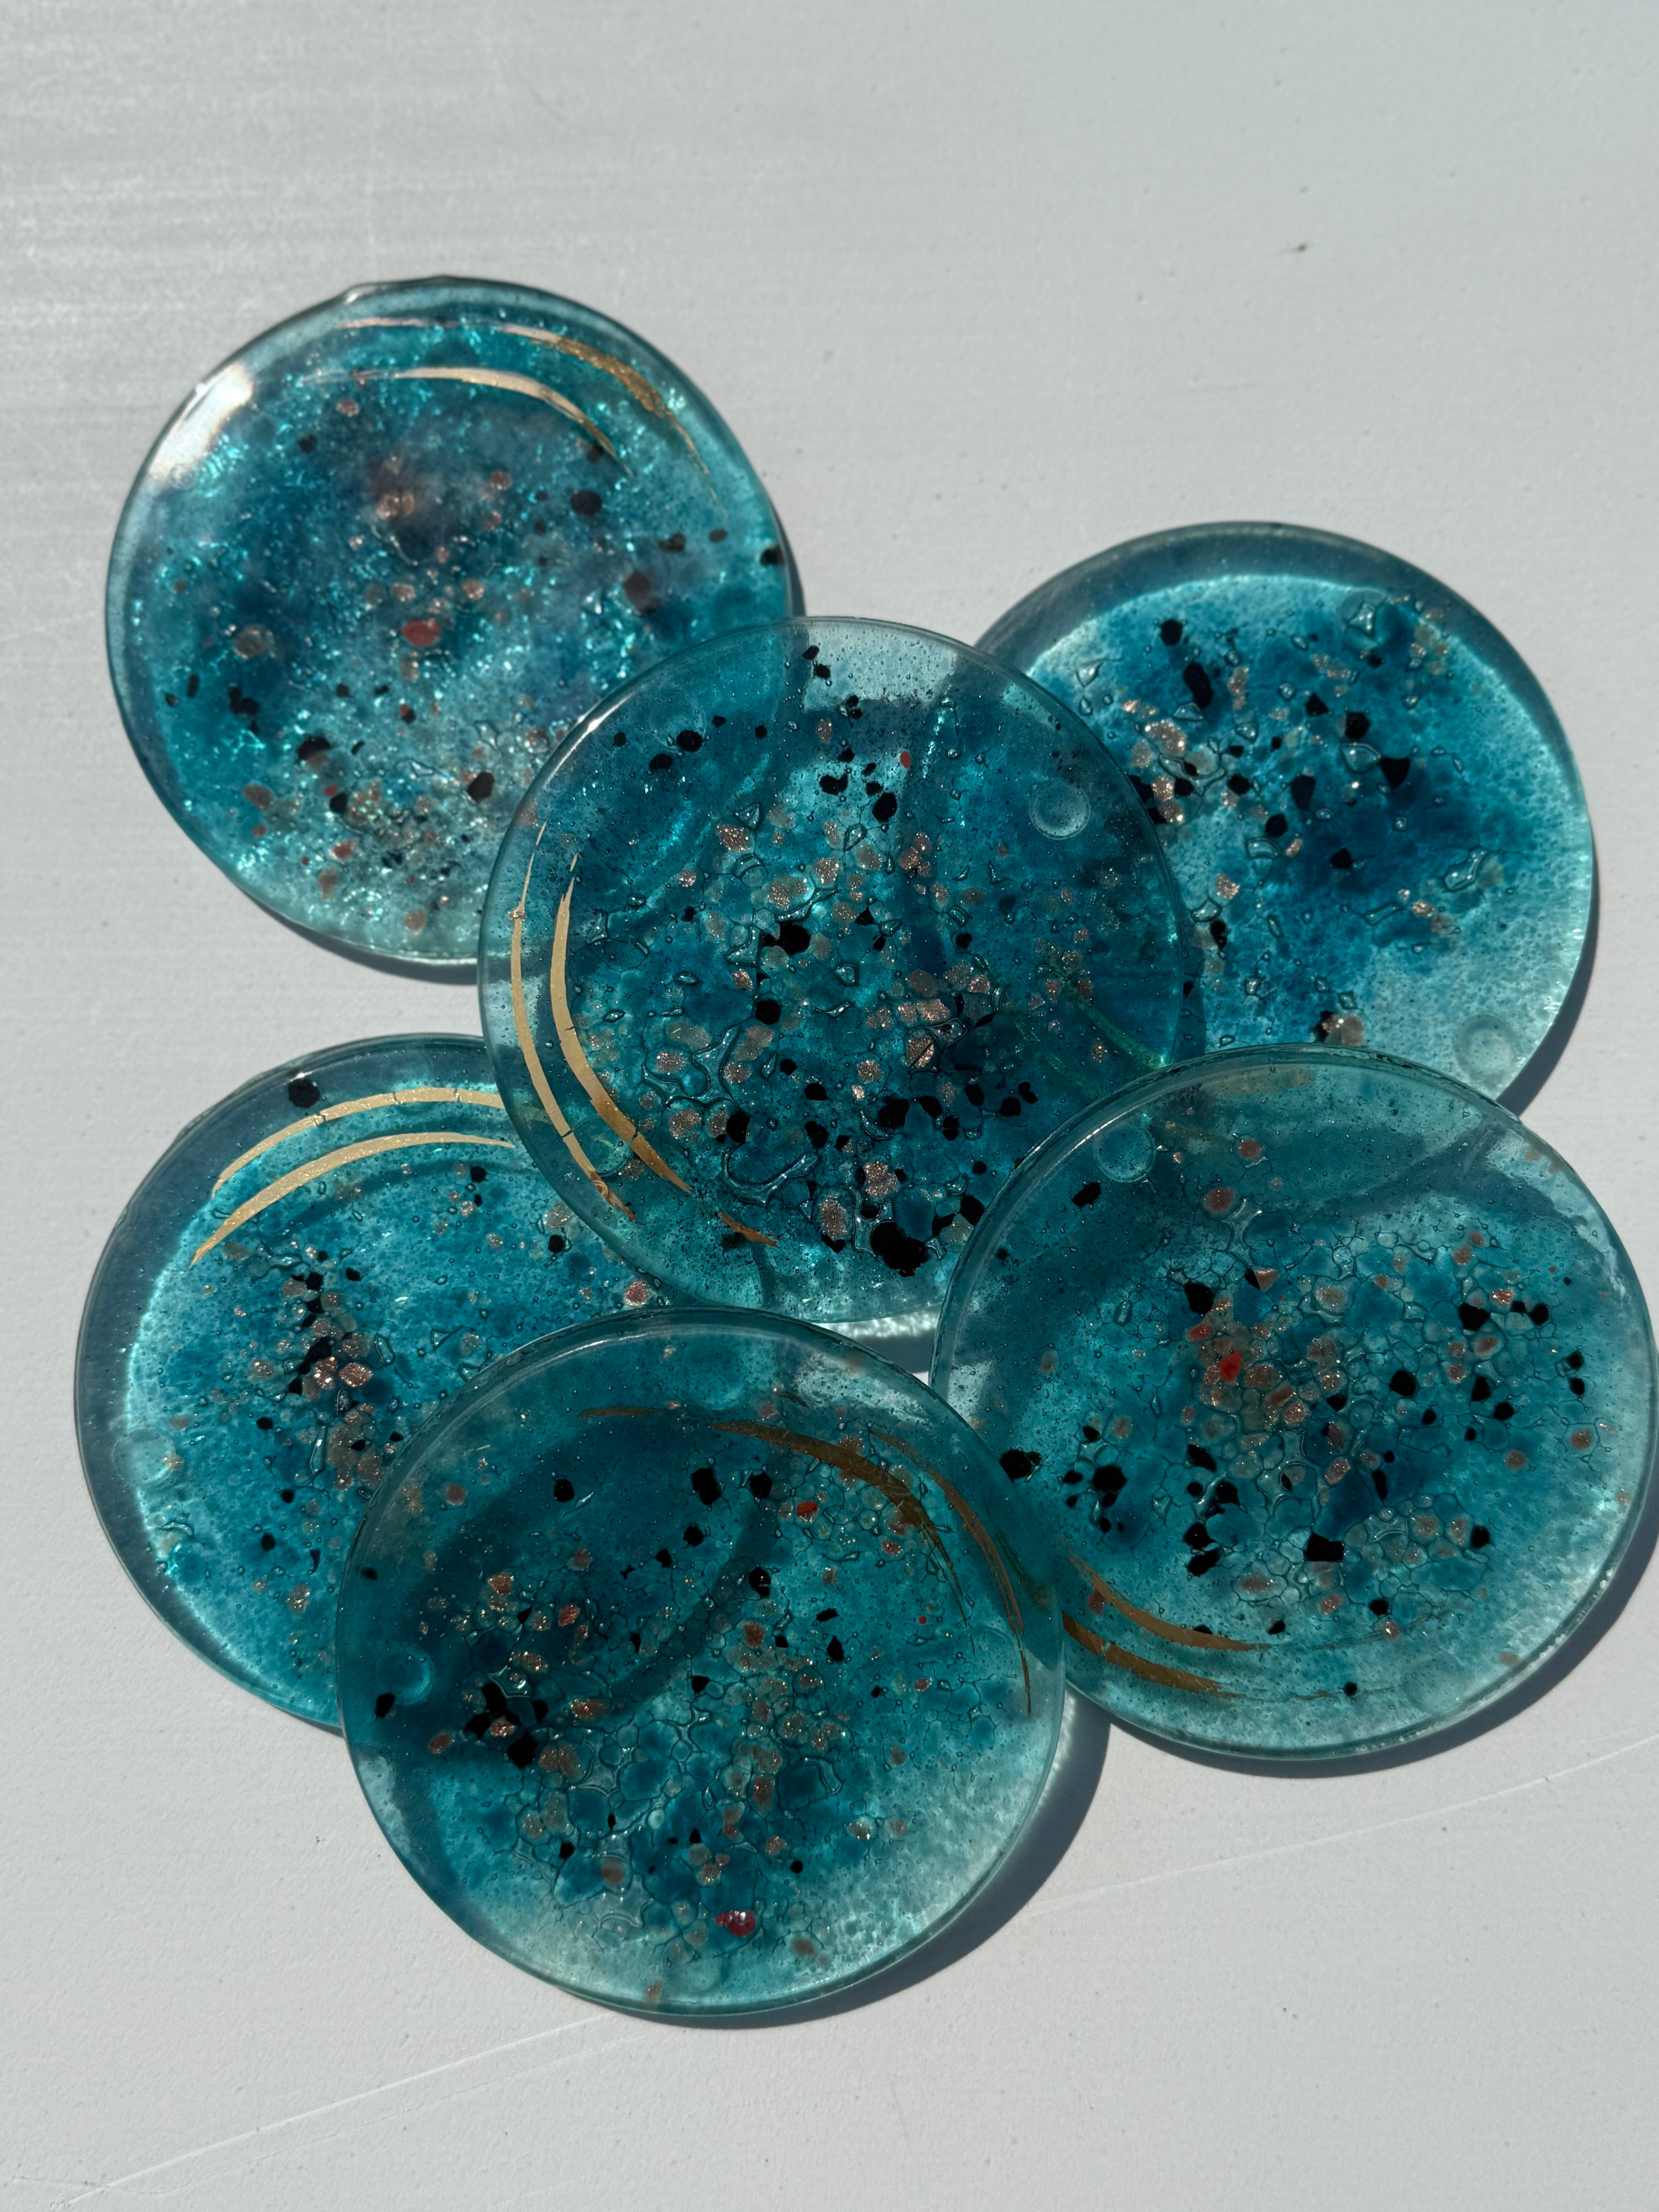
Aqua Round Glass Coasters

Aqua Round Glass Coasters
Regular price
£7.50
Tax included.
Minimum order quantity = Set of 2 coasters
Set of 4 = 5% off ~~ Set of 6 or more = 10% off
This round fused glass coaster is coloured in pale blue and sprinkles of gold/copper, along with brush strokes of gold.
Every set is handcrafted so subtle differences may appear in each coaster (as with all artisan crafted products), but the design principle behind their construction will be the same every time.